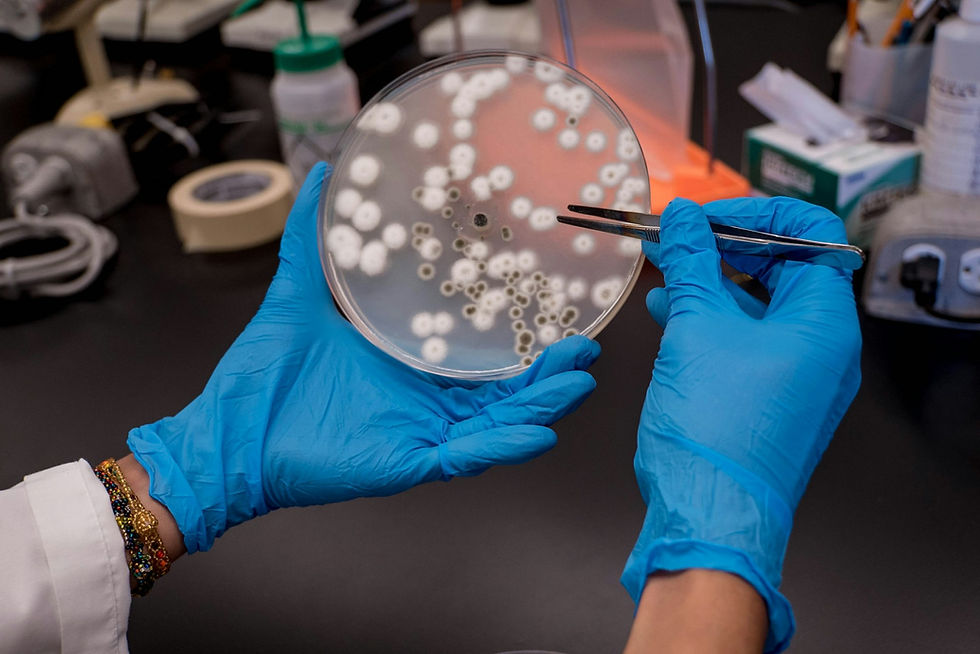
미생물 검사의 패러다임 전환, FDA가 신속 검사법(RMM) 병행 도입을 권고하는 이유

더웨이브톡, 워터코리아부터 ISH2025까지…국내외 전시회에서 주목받은 스마트 수질센서
- 2025년 4월 2일
- 1분 분량
최종 수정일: 2025년 4월 4일

“우와, 이건 주민들한테 꼭 나눠줘야겠네요.”
3월 19일부터 21일까지 일산 킨텍스에서 열린 워터코리아 2025 현장에서, 더웨이브톡 부스에 정말로 많은 분들이 찾아와주셨습니다. 특히 휴대용 탁도계 WaTalk(워톡)을 직접 사용해본 지자체 공무원들의 반응이 인상적이었습니다. “이거, 저희가 직접 구매해서 주민들께 나눠드리면 정말 좋겠습니다”라는 말씀을 남기실 만큼, 현장에서의 관심은 뜨거웠습니다.
또한 초소형 탁도센서 모듈, 인라인 탁도계 IQ-50, 스마트 수도계량기용 PipeTalk™ 등 다양한 제품에도 높은 관심을 보였습니다. “이 정도 크기에 (유지 보수 없이도 정밀한 측정이) 가능해요?”라는 피드백을 받으며 놀라워하시는 분들이 많았습니다. 주문형 반도체 기반 센서를 통해 탁도계가 도입되지 못했던 가전, 스마트계량기 등의 영역에서도 이제 수질측정이 되기 때문입니다.
더웨이브톡은 이번 행사에서 명함을 남긴 분들을 대상으로 WaTalk 증정 이벤트를 진행하였습니다. 이를 통해 더 많은 분들이 제품을 직접 체험할 수 있었고, 현장에서 바로 협업을 논의한 사례도 있었습니다. 제품을 직접 만져보고, 눈으로 확인하고, 손끝으로 느끼며 ‘이 정도면 현장에서도 바로 쓸 수 있겠다’는 확신을 얻으셨다는 반응이 특히 인상 깊었습니다.

한편 유럽 현장에서도 좋은 반응이 이어졌습니다. 더웨이브톡의 유럽 파트너사인 OCO Global은 AquaTech Amsterdam과 ISH 2025에 참가하여 당사의 기술을 소개하였으며, 이를 통해 글로벌 시장에서의 입지를 한층 강화하였습니다. 반도체 기반 유지보수 없는 구조, 초정밀 탁도, 소형화 및 확장성 등에 놀라며 협업 가능성에 대해 진지한 논의를 기대하게 했습니다.
현재 더웨이브톡은 국내외 선도 기업들에 시범 제품 공급을 확대하고 있습니다. “이번 전시 이후, 글로벌 물 산업 리더들과의 미팅이 추가로 이어지고 있다”며, “가정용부터 산업 및 공공 분야까지, ‘Water Quality Everywhere’라는 비전을 실현해나가겠다”는 뜻도 밝혔습니다.